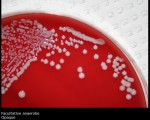

Featured Articles
 11 years ago
11 years agoWhite blood cells: Description, Classification and Formation
 11 years ago
11 years agoBlood Cells and Platelets
 11 years ago
11 years agoGram stain of wound specimen
All Stories

Iodamoeba buetschlii cysts
Cysts of Iodamoeba buetschlii vary from being nearly spherical to ellipsoidal, and measure 5-20 µm.
Cysts contain a single nucleus that is not visible in either unstained or iodine-stained ...

Myeloblast
– size : 15-20 µm
– nucleus : round , N\C: 7:1 , 4:1 , reddish purple with delicate chromatin and nucleoli (2-3 )
– cytoplasm : pale to deep blue (basophilic ) with ...

Charcot–Leyden crystals
Charcot-Leyden crystals are formed from the breakdown of eosinophils and may be seen in the stool or sputum of patients with parasitic diseases especially tissue-invading parasites ...

Auto-Antibodies
Autoantibody is harmful antibody that attacks components of the own body called self antigens.
Autoantibodies damage body tissues by phagocytosis (ingestion) or lysis (bursting) ...
Staphylococcus Saprophyticus
Staphylococcus saprophyticus is a Gram-positive, coagulase-negative bacterium.
S. Saprophyticus is a common cause of community-acquired urinary tract infections.
S. saprophyticus ...

Small vs Large lymphocytes
Small lymphocytes: These are the most common type in normal blood. They have a large, dense, round nucleus and thin basophilic cytoplasm and are capable of ameboid movement and the ...

The egg of Taenia spp
The eggs of Taenia spp. are indistinguishable from each other, as well as from other members of the Taeniidae.
The eggs measure 30-35 micrometers in diameter and are radially-striated. ...

Staphylococcus – Coagulase test
Coagulase is an enzyme that catalyzes the formation of a fibrin clot in plasma. Obvious clumping of the bacteria indicates the bacteria produces bound caogulase.
Staphylococcus aureus ...

Smudge Cells
are remnants of cells that lack any identifiable cytoplasmic membrane or nuclear structure.
Smudge cells, also called basket cells, are most often associated with abnormally fragile ...

Phenylketonuria Test
Phenylketonuria Test (PKU Test, Guthrie Test, Phenylalanine): Phenylalanine hydroxylase is an enzyme which converts phenylalanine to tyrosine.
A deficiency of this enzyme leads to ...


